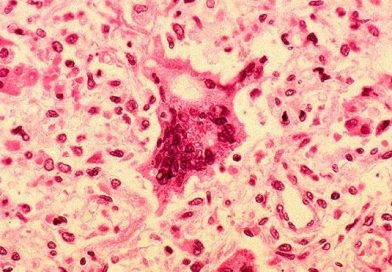
Nicaragua toma medidas preventivas ante casos de sarampión reportados en Costa Rica

En la Escuela Folklórica Trinidad Dávila, la Alcaldía de Masaya brindó un merecido reconocimiento a los miembros del Consejo de

Nicaragua Gobierno Instituciones

(+Fotos y Video) Turistas de varias nacionalidades que llegaron en el crucero Artania visitan León
Procedente de Puerto Huatulco, en México, arribó a Puerto Corinto el crucero Artania con 848 pasajeros y 543 tripulantes. Esta

Presentan ley para una cultura de diálogo, reconciliación y paz en el Caribe Norte
En Bilwi la compañera , titular del Ministerio de la Familia realizó la presentación de la ley 985, ley para

(+Fotos y Video) Llega a puerto de Corinto el Crucero Artania
Llega a puerto de Corinto el Crucero Artania. Esta entrada fue modificada por última vez el 14 de septiembre de

CARIÑO–VERDAD ! Nicaragua, Buena Voluntad !
Estos son Días de Buena Esperanza, y Nicaragua aplaude los esfuerzos que con Confianza Fraternal, estamos haciendo tod@s, todas las

(+Video) Clínicas móviles y brigadas de varios países llevan salud al pueblo nicaragüense
La compañera Rosario Murillo, vicepresidenta de la República, destacó este viernes todas las iniciativas nacionales y de voluntarios de países

(+Video) Humberto Vargas Carbonell: Hoy el patriotismo pasa a ocupar el centro de las grandes definiciones políticas
El doctor Humberto Vargas Carbonell, Secretario del Partido Comunista Vanguardia Popular de Costa Rica, dijo que el eje central del Encuentro Mesoamericano

(+Video) Compañera Rosario Murillo: Nicaragua aplaude todos los esfuerzos para tender puentes y avanzar a la paz
La compañera vicepresidenta Rosario Murillo, señaló este viernes que estos son días de buena esperanza y que el pueblo entero
Nicaragua toma medidas preventivas ante casos de sarampión reportados en Costa Rica
El Ministerio de Salud de Costa Rica reportó este jueves tres casos positivos de sarampión entre turistas franceses: un niño de cinco años y

Matagalpa: Realizan el lanzamiento oficial de la Ruta del Café en El Tuma – La Dalia
El Instituto Nicaragüense de Turismo (INTUR), junto a la Alcaldía de El Tuma – La Dalia, gabinetes de turismo del






